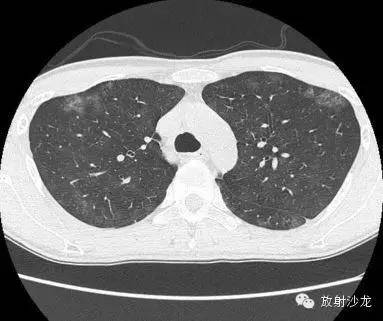
【病例】肺孢子菌肺炎影像表现1例

【病例】肺孢子菌肺炎影像表现1例
发布时间:2022-10-22
发布时间:2022-10-22
首次就诊胸片:

首次就诊CT:
两周后的CT和X线:





胸片示两肺中下野边界不清的磨玻璃样阴影(GGO)。CT示两肺地图样分布的GGO,主要位于两肺上叶、右肺中叶及两肺下叶,其中两肺下叶多发的GGO融合并伴有小叶间隔增厚。2周后随访胸片示双肺野弥漫分布的GGO增多。患者第一次就诊时未告知自己的性取向。只告知了曾接触过染发剂。患者按肺间质性疾病给予激素治疗。然而,治疗后患者的症状和影像学表现均加重。患者血液检测结果显示艾滋病病毒阳性。支气管肺泡灌洗液GMS染色示大量的卡氏肺孢子虫。
疾病简介:
肺孢子菌肺炎(pneumocystis pneumonia,PCP)过去称之为卡氏肺孢子虫肺炎(pneumocystis Carinii pneumonia,PCP),肺孢子虫一直被认为是一种原虫,以后发现其 DNA 与真菌非常接近,目前已将其列入真菌,更名为肺孢子菌肺炎。肺孢子菌肺炎是获得性免疫缺陷综合征(acquired immunodeficiency syndrome,AIDS,艾滋病)患者中最常见的机遇性感染,在AIDS患者全病程中可经历一次或多次PCP 的反复感染。
病理学改变:
卡氏肺囊虫(PC)属于原虫类寄生虫,PC对肺组织有较高的亲和力,可寄生于正常人的肺泡内,通常以包囊和滋养体两种形式交替存在,正常人体通过细胞免疫将其清除体外,只有在免疫损伤的条件下才致病。由于艾滋病患者CIM细胞减少,免疫力降低,清除肺囊虫的能力下降,使其在肺泡内繁殖。
早期卡氏肺囊虫滋养体吸附在肺泡壁上,破坏I型肺泡上皮细胞的细胞膜,使细胞坏死及毛细血管通透性增加。液体渗出到肺泡腔内,影像学表现为肺内粟粒样的浸润阴影:随后PC在肺泡腔内大量繁殖,引起炎性渗出及肺泡上皮增生,肺泡液内含有滋养体的嗜酸性渗出物及纤维蛋白和脱落的上皮细胞,呈实变状态,影像上表现斑片状阴影融合扩大为均匀致密的浸润阴影,呈典型的弥漫性毛玻璃改变;同时,Ⅱ型肺泡上皮细胞增殖修复受损的肺泡毛细血管间膜,肺问质内巨噬细胞、浆细胞和淋巴细胞增殖导致间质性肺炎,这种修复最终导致间质纤维化改变,肺部影像表现为纤维索条状、网格状及网结状改变。
影像学表现:
由于PCP病情发展快,病理表现复杂。因此其CT显示多样化,同时具有特异性。根据不同时期肺部CT的不同表现。将PCP分为早、中、晚三期。早期为渗出期,典型表现为肺内多发粟粒状小结节,以两中下肺野分布为主,可伴有肺门影增大。此时需要与急性粟粒型肺结核相鉴别,后者肺内病灶呈现典型的分布、大小、密度三均匀,而PCP的粟粒状病灶在肺尖部分布稀少,可与后者相鉴别;中期为浸润期,随着病变进展,粟粒及斑片状阴影融合扩大为均匀致密的浸润阴影,呈弥漫性毛玻璃改变,典型表现为以肺门为中心双侧对称,病灶自肺门向两侧肺间质浸润,由中肺向下肺发展,HRCT病灶显示更清晰,呈地图样或碎石路征,其内可见清晰的含气支气管穿过,肺尖部受累较晚,肺野外带透亮度增加,可见典型的“柳叶征”或“月弓征”,为代偿性肺气肿表现。上述典型表现可与大叶性肺炎、肺水肿等鉴别诊断;晚期代偿修复期,肺内病变以实变、纤维化为主,见大片状高密度影及索条状、网织状改变。
总结:
AIDS合并PCP的临床影像表现具有特征性,特别是CT检查可提供较多肺内病变诊断信息,影像表现及治疗后转归与P02和免疫关系密切。可以判断患者的治疗与预后,结合临床及实验室检查不难做出诊断。
上一篇:肺囊性病变的鉴别诊断
下一篇:【病例】肺隔离症1例CT影像表现